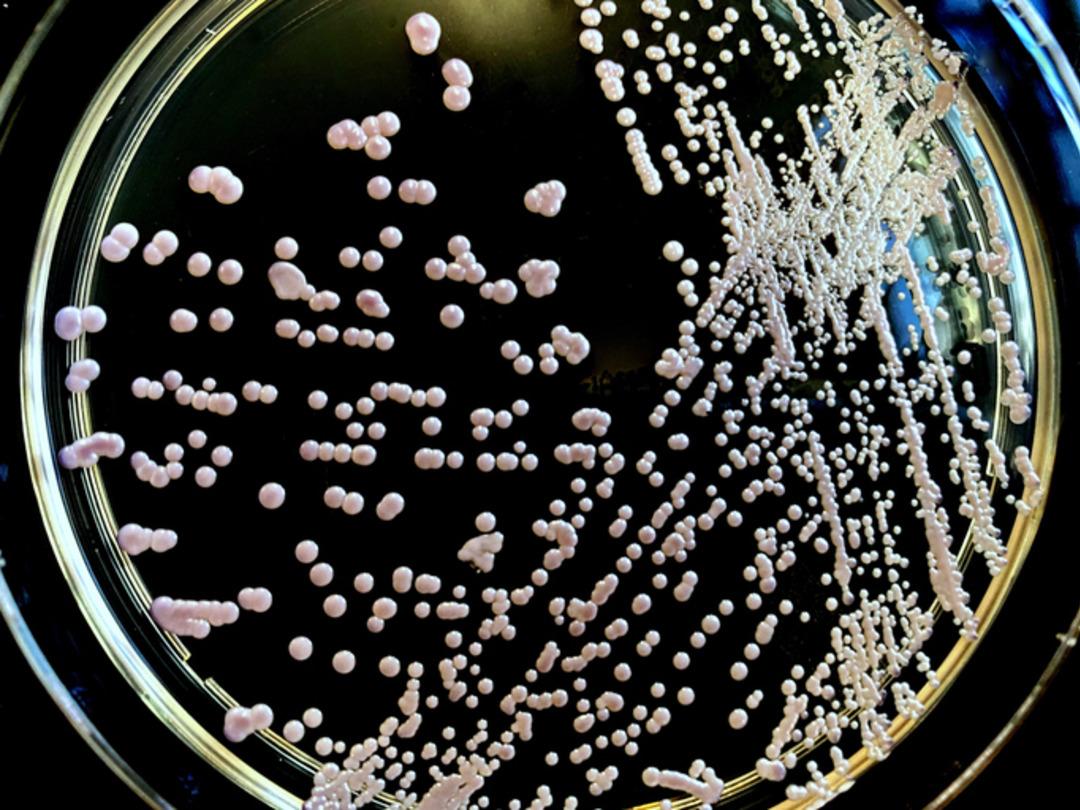
Süper böcek krizi! Alarm dünyada verildi: ekonomiyi ve sağlığı tehdit ediyor! Ölümler %60 artabilir! Süper böcekler sessiz midir? Uzmanlar:

Antibiyotiğe dirençli bakteriler, yani “süper böcekler”, tüm dünyadaki sağlık otoritelerini endişelendirdi. Bilim adamları, bu mikroorganizmaların neden olduğu ölümlerin 2050 yılına kadar %60 artabileceğini öngörüyor.
Birleşik Krallık’ta yapılan bir araştırmaya göre, antimikrobiyal direnç (AMR) küresel bir felakete dönüşebilir. Amerika Birleşik Devletleri’nde yılda 1.34 milyon, Birleşik Krallık’ta 184 bin kişi süper böcekler nedeniyle ölebilir.
Uzmanlar, sağlık sistemlerinin enfeksiyon yapma riskinin lanetlenemediğinin altını çiziyor.
Süper böcek krizi: Hangi ülkeler daha fazla etkilenecek?
Araştırma raporuna göre, süper böceklerin en ağır darbeyi etkileyeceği bölgeler ABD, İngiliz ve Avrupa ülkeleri olacak. Çalışmanın ortasında yayıncı Anthony McDonnell, AMR programlarının finansal kesintilerden korunması gerektiğini, aksi takdirde dirençli mikroplar hızla yayılması gerektiğini söyledi.
McDonnell, “Bu krizin dünyanın her yerine en çok etkilenen ülkelerden yayılabileceğini söyledi.

Ekonomik Tsunami: Süper böcekler işgücünü ve ekonomiyi etkileyecektir!
122 ülkeyi kapsayan bir çalışma, süper böcekler durdurulmazsa, küresel ekonomide büyük bir çöküşe yol açabileceğini göstermektedir. 2050 yılına kadar Çin GSYİH’sında 722 milyar dolar, Amerika Birleşik Devletleri’nde 295.7 milyar dolar, AB’de 187 milyar dolar, Japonya’da 65,7 milyar dolar ve Birleşik Krallık’ta 58,6 milyar dolar kaybedilebilir. Bu sadece sağlık sistemleri için değil, aynı zamanda küresel işgücü için de bir tehdittir.

Çözüm nedir?
Uzmanlar süper böcek tehdidine karşı küresel bir mücadele istiyorlar. Anthony McDonnell, Anthony McDonnell, “Bakteriyel enfeksiyonların tedavisine yatırımlar milyonlarca hayattan tasarruf edebilir ve milyarlarca dolar ekonomik kaybı önleyebilir.
Antibiyotik direnci ile mücadele etmek için daha fazla kaynak ve sağlık sistemi güçlendirilmelidir. Aksi takdirde, süper böcekler hem yaşamlarını hem de ekonomilerini tehdit etmeye devam edecektir.
